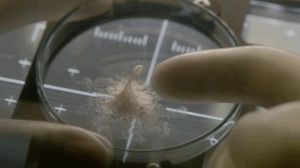

Gott damn that was a packed three months since I’ve been here last. Let’s see how much I want to clutter your life with my travails.
Longtime readers (there are a least a couple) will recall that the fallout of the COVID years finally caused me to declare bankruptcy, and for a couple of years that was the norm. The garnishing of my paycheck and my wife’s were good practice for surviving on Social Security, which I in fact will likely never get to collect because my idiot countrymen could not bring themselves to vote for a black woman. (as a digression, there is a reason that whoever or whatever is in charge of the universe did not give me super powers, the reason being the death toll would have been quite extreme)
Things changed when a local power play caused me to unwillingly change employers, and at almost the same time, my wife (who had to shut down her school for autistic children) had to quit her new job because her health would not allow it.
In brief – the bankruptcy case was dismissed, at which time we found out that the trustee had not done much at all about the mortgage on our house. All that I can say for sure was my car note got paid off, so that’s something. Foreclosure was a very real possibility. We found someone who would buy the house, getting us out of that deep hock hole, but we had to pack and leave pretty precipitously.
We had been in that house for 24 years, and if you know me at all, that means the house was stacked with stuff that had caught my fancy throughout my life. The house we were moving into (it’s a rental) was smaller, so a lot of it had to go. In a philosophical sense, a lot of it required some labor to access, moving other crap out of the way. Lightening the load was utterly necessary, and doubtless a long time coming, but it still felt wrong.
I had been told several times that I was an episode of Hoarders waiting to happen, but I replied that was nonsense. I wasn’t hoarding, I was curating.
This is where some asshole would doubtless crop up to say, “Okay, then – Pop quiz! What’s important to you?” (Super-powered me would let him live, but only after thinking about it hard) A lot of my books got the chop – my eyesight is failing, anyway, right? I tried to limit myself to three boxes of books. That of course grew to six, and yeaaaaaaaaah, I’m still not sure I held to that, either.
(One thing that surprised the living hell out of me was when I decided to keep my Cerebus phonebooks. The first four of those are first-rate satire, and even though Dave Sim deteriorated into a loon, those were a big part of my life while I was still collecting floppies.)
(Don’t come after me about problematic creators. All my Neil Gaiman stuff made the trip, as well)
(also the Harry Potter film box set, because I’ve only seen the first)
(Anyway.)
Most of my figures are gone, too (I was a big Macfarlane collector in the 90s). A box of swords I had collected over the years, most of which were costume trash, anyway. My swordfighting days are long gone.
So I concentrated on movies.
DVD Profiler says I have almost 3300 discs in my collection. That number is dubious, because I wasn’t good about keeping the database current when I did get rid of discs. I know not all of these made the trip, too, as they were in the garage, and as said before, I couldn’t get to them easily, so what was the point? It was like not owning them at all.
The advantage to the new place is my son is married and no longer living with us, so I finally got my wish: the extra bedroom is mine to line with shelves and get those movies out of boxes and more readily accessible. There is that scurrilous database, though, so I am shelving them slowly, going through the boxes and so far, isolating A through E, and I will comb through the database and finally delete everything that’s not actually here. A slow process, but ultimately worth it, I think.
There are exceptions to that process. All my Marvel movies were together, and now they’re on their own, dedicated shelf. I am missing my copy of Quantumania, which is causing one of my eyes to twitch somewhat alarmingly.
Now I am back about a week later, and the eye-twitching has settled down. I’m pretty sure I know where my copy of Quantumania is located currently, and frankly, it was just easier to buy a new copy. I am pleased to say I have carved out enough time from unpacking other stuff and having my time wasted at City meetings to actually get through the letters A and B (and the movies with numbers for titles), and while my heart isn’t totally broken, there are some missing titles that I do regret, and some whose absence mystify me. The Best Years of Our Lives? I had that in a place of honor, where did it go?
How in the living hell did I wind up with two copies of Breakfast at Tiffany’s? One I know was a gift, but the other… I mean, the fact that I wound up with three copies of The Brainiac is understandable, but Breakfast at Tiffany’s?
Okay, enough of my trials and title tribulations – this could go on forever. At this point, I have finished letters A through E, and in attempting to continue with F and G, I have found no fewer than 30 titles starting with A through E that I missed in my first sorting run. To quote the famous philosopher Charlie Brown, “Good grief!”
Now back to the cataloging.